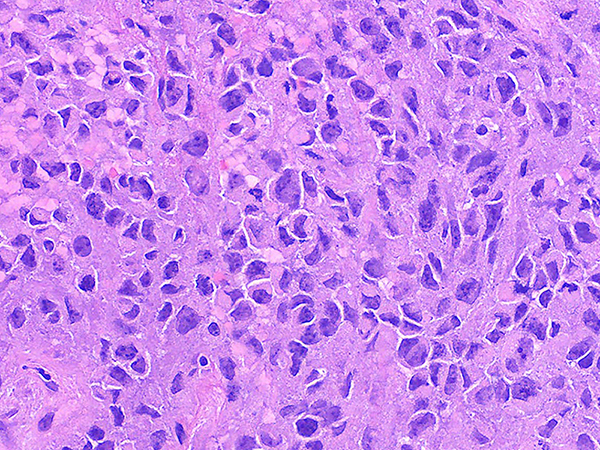

Click here to see all images
June, 2020
Case of the Month
Clinical History: Middle aged man with a large central lung tumor. Endobronchial biopsies demonstrate a poorly differentiated high grade neoplasm with abundant necrosis (Figures 1-2). The tumor is composed of round to oval discohesive cells with prominent nucleoli, abundant mitotic activity and a relatively monomorphic appearance (Figures 3-5). Numerous rhabdoid cells with distinctive eosinophilic cytoplasmic inclusions indenting eccentrically located nuclei are present (Figures 3-5). The neoplastic cells are negative for all cytokeratins including, 7, 5/6, AE1/AE3, OSCAR and cam 5.2. The cells are negative for neuroendocrine markers synaptophysin, chromogranin, and CD56. The cells are also negative for CD45, TTF-1, p40, NUT, SOX10, CD31 and desmin. The cells have intact expression of INI-1. The neoplastic cells demonstrate complete loss of BRG1 expression (Figure 6).
Quiz:
Q1. What gene encodes the BRG1 protein
- SMARCA4
- SMARCB1
- SMARCA2
- BRD4
Q2. Which of the following is the most likely history for a patient with a SMARCA4 deficient thoracic sarcomatoid tumor?
- Peripheral slow growing lung mass
- Never smoker
- Carrier of a germline variant in SMARCA4
- History of heavy smoking use (>20 pack-years)
Q3. The dyscohesive cells in a SMARCA4 deficient thoracic sarcomatoid tumor typically show loss of which adhesion molecule?
- E-cadherin
- Claudin-4
- P-selectin
- E-selectin
Answers to Quiz
Q2. D
Q3. B
Diagnosis
Discussion
These tumors have a characteristic appearance with discohesive high-grade round cells and focal rhabdoid cells with eosinophilic inclusions that indent the eccentrically located nuclei (Figures 3-5). These tumors typically have a more monomorphic appearance but have prominent nucleoli, abundant mitotic activity and necrosis. Expression of the cell adhesion molecule Claudin-4 and the SMARCA2 protein (another major catalytic subunit of SWI/SNF complexes) is also typically lost in these tumors.
These tumors are extremely aggressive and have a dismal prognosis with a median survival on the order of 5.2 months. The tumors are typically large central masses that can have rapid growth and bulky peritoneal metastasis which can complicate the identification of the primary tumor sites. In the reported cases there is a relative paucity of brain metastases. There is some evidence that tumors with SMARCA4 deficiency may respond to EZH2 inhibitors and the high mutational burden raises the possibility of immune checkpoint inhibitors for the treatment of these aggressive malignancies.
SMARCA4 deficiency has also been reported in non-small cell carcinomas which lack the sarcomatoid appearance with discohesive round cells and interspersed rhabdoid cells. These tumors tend to be positive for Claudin-4 and express SMARCA2. In some cases a transition between a non-small cell carcinoma and a SMARCA4-deficient thoracic sarcomatoid tumor has been observed suggesting that these entities may be related. Cases with a non-small cell carcinoma morphology with BRG1 loss are also aggressive tumors but have a better prognosis compared to SMARCA4-deficient thoracic sarcomatoid tumors.
Take home message: Consider the possibility of a SMARCA4-deficient thoracic sarcomatoid tumor in patients with large rapidly growing tumors with relatively discohesive monomorphic cells with a focal rhabdoid appearance. These are best identified using antibodies against the BRG1 protein which is encoded by the SMARCA4 gene.
References
Rekhtman N, Montecalvo J, Chang JC et al. SMARCA4-deficient thoracic sarcomatoid tumors represent primarily smoking-related undifferentiated carcinomas rather than primary thoracic sarcomas. J Thorac Oncol 2020;15:231-247.
Sauter JL, Graham RP, Larsen BT, Jenkins SM, Roden AC, Boland JM. SMARCA4-deficient thoracic sarcoma: a distinctive clinicopathological entity with undifferentiated rhabdoid morphology and aggressive behavior. Mod Pathol. 2017;30(10):1422-1432.
Yoshida A, Kobayashi E, Kubo T et al. Clinicopathological and molecular characterization of SMARCA4-deficient thoracic sarcomas with comparison to potentially related entities. Mod Pathol 2017;30:797-809.
Contributor
cecchini.matthew@mayo.edu
Pulmonary Pathology Fellow
Mayo Clinic
200 First Street SW
Rochester, MN